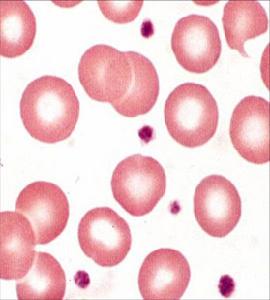
新生兒失血性貧血

概述
根據國外統計資料,新生兒失血性貧血(Bloodlossanemiaofnewborn)在嚴重貧血中占5%~10%;在新生兒重症監護病室的嬰兒有25%其紅細胞容量<25ml/kg其中大部分由於失血引起。
病因
 血小板
血小板(1)胎兒-胎盤出血:指胎兒出血至胎盤而引起新生兒貧血,可出血至胎盤實質或出血導致胎盤後血腫,常見有以下兩種情況:
①臍帶繞頸:當臍帶繞頸時因臍靜脈壁薄,收縮臍帶的壓力首先阻塞臍靜脈,然後才是臍動脈,故胎兒不能得到從臍靜脈來的胎盤血,而臍動脈仍繼續將胎兒血回流至胎盤胎兒失血嚴重者,可喪失20%的血容量
②剖宮產手術後:結紮臍帶前如嬰兒位置高於胎盤這時通過臍動脈的血繼續流向胎盤而由於流體靜力的壓力,阻礙了血從臍靜脈繼續回流至胎兒有報告剖宮產嬰兒血容量較陰道分娩者低。
(2)胎-母輸血:
①臍動脈和絨毛間隙存在壓力差:臍動脈和絨毛間隙存在壓力差,胎兒水分及代謝產物可達母體,因此胎兒血亦可循此途徑,特別是絨毛有破損時,血可直接進入母血循環,有人檢查妊娠各期胎盤,發現胎盤屏障有不少小裂口健康搜尋此乃繼發於血管的阻死和絨毛梗死。
②經腹羊膜穿刺術:經腹羊膜穿刺術已廣泛用於處理新生兒溶血病及圍生期遺傳代謝性疾病診斷,穿刺針頭可損傷胎盤引起出血曾有報告10.8%胎-母輸血發生於診斷性羊膜穿刺後。
③其他損傷:外倒轉術、靜注催產素、母親妊娠高血壓綜合徵等
④胎盤絨毛膜、血管瘤、絨毛癌等:胎兒紅細胞最早可在妊娠4~8周通過胎盤進入血液循環,也可在臨產時發生
(3)胎-胎輸血(fetofetaltransfutsion):雙胎輸血是單絨毛膜雙胎妊娠的一個合併症其圍生期發病率及死亡率均高,1941年Herlitz首先報導,目前對其臨床表現已有較多的認識,但發病機制仍不清楚,近年來在病因研究方面有一定進展因此在處理上也有所突破,增加了存活率。
發生雙胎輸血的重要條件是雙胎胎盤間具有共同的胎兒血管床根據胎盤血管注射牛奶的研究,單絨毛膜雙胎幾乎全存在這種血管吻合,有動脈間,靜脈間,毛細血管間的吻合,但多發生在動,靜脈交通型,這是1882年Schatz提出,稱之為“第三循環”,供血兒動脈血至胎盤絨毛葉,從靜脈回流入受血兒,此病的發病機制已受到下列新的概念的挑戰:
①雙胎間血清蛋白濃度區別:1963年Kloosterman提出供血兒通過血管吻合慢性丟失蛋白至受血兒循環,因蛋白不能通過胎盤,低蛋白血症的供血兒循環中膠體滲透壓低水分回流至母親體內。患兒脫水和生長落後;而高蛋白血症的受血兒其膠體滲透壓高從母體吸收大量水分,患兒生長較快,羊水過多,並可致全身水腫。
②雙胎間心鈉素水平區別:1989年Nageotte發現受血兒心鈉素水平高於供血兒,心鈉素釋放是由於血容量增加刺激而產生的同時可促使胎兒尿產生增加,導致羊水過多,1992年Wieacker也同意此結論,指出羊水增多是由於抗利尿激素釋放受抑制所致。
③帆狀胎盤:1993年Fries等指出單絨毛膜妊娠合併帆狀胎盤者雙胎輸血多於不合併者他們認為膜狀臍帶易受壓,血流通過臍靜脈到一個雙胎的量減少,而較多的血會通過胎盤血管吻合處流至另一胎兒,致羊水產生過多,又可反過來壓迫臍靜脈造成惡性循環,作者指出穿刺抽出大量羊水,不僅可緩解症狀也可作為直接病因治療。
④雙胎間胎盤功能的區別:1992年Saunders等提出雙胎輸血的病因是供血兒的子宮胎盤功能不全,胎盤循環周圍阻力增加,通過血管吻合促進血分流至受血兒,1993年Vetter提出小的胎兒胎盤功能不全和生長障礙的反應是釋放出生長刺激物,但因本身胎盤功能不全而無法對此刺激物起反應;而另一胎兒其胎盤功能正常,通過血管吻合此生長刺激物流入,受刺激後促進生長,此過程即稱為“生長因子後果”(growthfactorsequence)多由於分娩時產科意外情況胎盤及臍帶畸形而引起生後失血以臍部胃腸道和內出血多見,近年來由於醫院性診斷性取血而引起失血也有所增加。
2.產時失血多由於分娩時產科意外情況、胎盤及臍帶畸形而引起。
(1)胎盤異常:嚴重失血常發生於前置胎盤、胎盤早期剝離或剖宮產時誤切胎盤而致失血,胎盤畸形以多葉胎盤較常見每一葉發出一脆弱靜脈分支至胎盤,該血管易破裂出血。
(2)臍帶異常:正常臍帶可由於過度牽扯而突然出血,臍帶畸形如臍帶血管瘤、迷走血管等後者是臍帶達到其植入處前分出1條或多條血管,其血管壁薄,缺乏臍帶膠樣組織的保護極易破裂;臍帶帆狀植入胎盤,血管亦在無保護情況下穿過羊膜和絨毛膜之間,出血發生率為1%~2%。
 新生兒失血性貧血
新生兒失血性貧血(1)臍部失血:原因可由於:
①斷臍時臍帶結紮不緊或臍帶殘端血管再度開放而出血。
②經臍帶靜脈插管進行換血換入庫存會有過多保養液的低血紅蛋白血。
③多次做診斷性臍靜脈取血。
(2)腸道失血:由新生兒出血症、先天性腸道畸形或壞死性腸結腸炎引起
(3)內出血:多由產傷引起,貧血常在生後24~72h出現,多伴有黃疸有以下幾種情況:
②顱內出血:如硬腦膜下及蛛網膜下腔出血。出血量大者可致貧血窒息缺氧所引起的早產兒腦室出血,出血量可達10%~15%患兒血容量。
③肝、脾破裂。
④腎上腺出血。
發病機制:
新生兒失血可由於胎盤的異常分離(胎盤早剝),前置胎盤,產傷造成健康搜尋的臍帶撕裂,胎盤內臍帶呈帆狀附著撕裂血管,剖宮產時切入前置胎盤所引起。如果分娩時臍帶緊緊纏繞在胎兒頸部或身體,動脈血可從胎兒泵入胎盤,同時由於臍帶受阻,妨礙了血液通過臍靜脈回流到嬰兒;分娩時立即夾住臍帶可能造成嚴重的急性隱性失血(進入胎盤)。
在宮內的胎-母出血可造成嚴重程度不等的隱性失血。這種出血可能是急性或遷延性,也可能鶒是慢性和反覆性的。如果胎兒有對出血的代償,其血細胞比容的下降會有一段時間(因為血容量再擴張)。急性圍生期出血會導致胎兒或新生兒休克,血細胞比容的下降需要經過數小時。對母血的Kleihauer試驗陽性可證實胎母出血;當有胎兒紅細胞進入母親血循環後,其抗酸洗脫的特性可為血塗片確定
慢性胎-胎間的輸血可發生在單卵雙胎,他們共同的胎盤之間有血管相通。至宮內(在供血雙胎)隱性失血。
症狀
紅細胞
紅細胞取決於出血量的大小和出血時間速度,小量出血可無症狀。
1.一般表現輕度失血的新生兒出生時並無症狀。分娩時發生的急性經胎盤失血,出生時新生兒貧血不明顯,但可引起低血容量性休克,需與蒼白窒息鑑別,前者給氧症狀不能緩解,後者吸入氧後症狀緩解。新生兒生後隨著細胞外液不斷進入血液循環以代償低血容量,24h後病兒可出現貧血,但無肝脾腫大。宮內慢性失血者,出生時即有顯著貧血,除蒼白外,其他症狀常不明顯,甚至Hb低至40~60g/L症狀仍較輕微,但可有肝脾腫大。嚴重的病例可發生充血性心力衰竭。病兒為小細胞低色素性貧血健康搜尋,網織紅細胞增高鶒,血清鐵減少。出血速度不同的表現:
(1)急性失血:多為產時失血,生後不久蒼白、煩躁不安呼吸淺快不規則甚至呼吸窘迫、心動過速、脈搏細弱。出血量多時有休克症狀,一般無肝脾腫大
(2)慢性失血:多為產前失血,顯著蒼白但呼吸窘迫不明顯,偶見充血性心力衰竭,多有肝脾腫大。
2.不同病因失血表現
(1)產前失血:發生胎-母輸血時,偶見胎、母血型不合,孕母可出現輸血反應,如寒戰、發熱、甚至急性溶血引起急性腎功能衰竭。
(2)雙胎間發生輸血:在單絨毛膜雙胎妊娠雙胎間發生輸血的發生率為4%~35%。雙胎間發生輸血的時間尚無一致看法健康搜尋,多認為是慢性失血過程但也可在分娩時發生或轉為急性輸血,後者供血兒表現為急性失血性休克;慢性失血過程所致的本病,供血兒表現蒼白,Hb可比受血兒低50g/L以上發育遲緩、體重可比受血兒輕20%。重者可出現水腫、肝脾腫大、尿少及羊水少。貧血嚴重時可表現呼吸急促等心力衰竭症狀,甚至死於宮內。相反,受血兒則表現為個體大,多血貌心、肝、腎、胰及腎上腺增大,尿多、羊水多,血液、紅細胞增多黏稠度增高高膽紅素血症及充血性心力衰竭等。偶見受血兒的血液經動脈吻合支流向死亡的供血兒,導致低血壓貧血,並可繼發腦部缺氧缺血性損傷。雙胎輸血可伴發無心畸形即供血兒無心臟,2個胎兒靠受血兒1個心臟供血,發生率約占單卵雙胎妊娠的1%。也常同時伴發單臍動脈畸形及帆狀胎盤。
雙胎輸血發生越早,預後越差如不治療圍生期病死率幾乎鶒是100%。孕28周前診斷及處理者,圍產兒病死率在20%~45%,明顯高於雙羊膜囊雙絨毛膜無胎兒間輸血的雙胎兒。
(3)頭顱血腫:又稱骨膜下血腫,常位於一側或兩側頂骨部,局部皮膚不腫,不變色由於骨膜下出血緩慢血腫多在生後數小時或2~3天才明顯,1周內達最大範圍,以後漸吸收縮小。血腫界限清楚,不越過骨縫,有波動感,局部皮膚顏色無改變藉此可與產瘤(先鋒頭)及帽狀腱膜下血腫鑑別後兩者的範圍均可超越骨縫,產瘤出生時即發現,界限不分明,壓之柔軟且可凹無波動感,局部皮膚可呈紅或紫色;頭顱血腫與帽狀腱膜下血腫的鑑別見下文頭顱血腫位於枕骨部位者,需與腦膜膨出鑑別,後者捫之隨呼吸有起伏感,頭顱X線片可見局部顱骨有缺損,而頭顱血腫顱骨完整,偶見顱骨有線樣骨折巨大頭顱血腫可致失血性貧血及高膽紅素血症。頭顱血腫吸收較慢,因大小不同可在2周至3個月左右消退吸收時先在血腫邊緣形成隆起的骨化的硬邊,中央凹陷,呈火山口樣改變。
(4)帽狀腱膜下血腫:生後不久即見頭皮局限性腫脹,出血可通過軟組織擴散,出血量較少時血腫範圍較局限,有的可被產瘤所掩蓋,出血量多時,腫脹範圍逐漸擴大,可累及整個頭皮,甚至波及額、眼周、枕或頸背部。血腫有波動感,常使前囟不易捫清,所覆皮膚可呈青紫色。出血嚴重時可致貧血或低血容量休克,若不及時治療可引起死亡
(5)肝臟破裂:可因臀位產、巨大兒、急產、復甦時擠壓胸腹部、宮內缺氧及凝血機制障礙等所致,也有報導順產的新生兒因肝臟血管瘤、胚胎性腫瘤破裂而引起出血者。肝受傷的初期先在肝包膜下形成血腫,待出血量增多肝包膜破裂則引起腹腔內出血。因此,早期症狀常不明顯多在生後48h內出現症狀表現為拒奶不安、蒼白、呼吸急促心率快、黃疸、肝臟增大右上腹可捫及腫物。待血腫增大或破裂,則出現急性失血性休克、腹脹移動性濁音,臍部偶呈藍色即cullen征。若病情急,可因失血性休剋死亡,甚至在生前診斷還有一定困難。本病診斷需靠腹部超音波檢查,或腹腔穿刺有血性液體,但穿刺無血性液體也不能排除內臟出血。治療需輸血抗休克,外科剖腹探查,進行治療
(6)脾臟破裂:可單獨發生或與肝臟破裂同時發生尤其是胎兒有脾腫大者,治療同肝臟破裂。
(7)腎上腺出血:據報導發生率為1.7‰,多見於臀位巨大兒或糖尿病母所生的嬰兒,剖宮產兒未見有發生者。腎上腺出血的原因尚不明,可見於分娩損傷、缺氧或重症感染的應激,腎上腺神經母細胞瘤破潰也可致大量出血,北京兒童醫院曾見1例生後15h雙側腎上腺巨大血腫破裂入腹腔致失血性休克,病理診斷為神經母細胞瘤火罐網。腎上腺出血90%為單側,多見於右側。新生兒腎上腺相對較大毛細血管豐富,其周圍缺乏間質支持,容易受傷和出血。右側腎上腺位於肝和脊柱間易被擠壓,其靜脈直接開口於下腔靜脈,受靜脈壓高的影響,受傷後易引起出血少量出血可無症狀,僅在較大的嬰兒X線片或屍檢中見到鈣化灶。大量出血可引起休克、青紫,腹部膨隆腎區可觸及腫塊,雙側腎上腺出血可出現一過性腎上腺皮質功能不全的症狀。腹部超音波檢查可明確診斷,但重症者常在屍檢時才被確診。治療除抗休克外,應按急性腎上腺皮質功能不全處理,加用氫化可的松5mg/(kg·d)靜脈點滴。
(8)腎臟損傷:臀位產時可引起腎破裂或腎蒂撕脫,生後不久出現血尿,腹部漸膨隆,有腹水並可捫及可移動的腎腫物。出血量多時則有貧血及失血性休克等。腹部超音波檢查可明確診斷。鑑別診斷包括腎臟,腫瘤伴發出血及腎靜脈血栓形成或梗死。治療與肝破裂相同,剖腹探查若腎有廣泛出血壞死則應作腎切除術。
併發症:
重症可發生心力衰竭。出血量多時常並發休克,慢性失血多並發貧血、肝脾腫大。
診斷:
根據臨床表現和實驗室檢查確診。
1.胎-母輸血為隱匿性,除臨床表現貧血,無黃疸外,診斷有一定困難,常需依賴以下各種試驗:
(1)母血循環中找到胎兒紅細胞:診斷時應注意:
①排除母親有任何使胎兒血紅蛋白增加的疾病。
②母、子如有ABO的血型不合胎兒紅細胞進入母血循環後極易清除,故酸洗脫法檢查應在分娩後數小時內進行,否則易出現假陰性,其他檢查方法包括直接區別凝集試驗,螢光抗體技術等但方法較複雜不常套用。
(2)母血胎兒血紅蛋白定量檢查。
(3)甲胎蛋白(alphafetoprotein)定量檢查。
2.雙胎輸血
(1)過去診斷方法:
①供血兒胎盤蒼白,萎縮;受血兒胎盤充血,紅色肥大,注射牛奶或有色溶液可證實血管吻合存在但實際上這種血管吻合併不容易發現。
②雙胎體重相差>20%,血紅蛋白相差>50g/L及雙胎臨床表現,有學者發現雙絨毛膜雙胎亦可有相似情況,並認為受血兒不一定血紅蛋白增加,供血兒亦可因代償性紅細胞生成素增加,而使兩胎間血紅蛋白區別不明顯。
(2)新的診斷方法:最近提出新的診斷方法:
①產前B超檢測:根據雙胎間腹圍相差>20%,羊水量不等,胎兒水腫,來確定雙胎輸血
②胎兒臍動脈都卜勒速率測定:觀察血流型,雙胎間有收縮/舒張比率的差異。
③臍帶穿刺:可除外染色體異常、先天性宮內感染引起的宮內生長遲緩
3.出生後出血見溶血性貧血,新生兒出血症、瀰漫性血管內凝血等,注意鑑別。
鑑別診斷:
需與以下疾病鑑別:
1.蒼白窒息出生前多有分娩合併症或宮內窘迫,新生兒有青紫呼吸困難或暫停、心率減慢及無Hb降低等可與本病鑑別健康搜尋。
2.重症新生兒溶血病也可有蒼白貧血,但常伴水腫、肝脾腫大,生後24h內即出現黃疸,可與本病鑑別確診溶血病需靠特異性血型抗體檢查。
檢查
 新生兒失血性貧血
新生兒失血性貧血1.血常規檢查急性失血為正細胞正色素貧血慢性失血為小細胞低色素貧血。雙胎間輸血受血兒有紅細胞增多,血紅蛋白增高,而失血兒紅細胞血紅蛋白顯著減少。
2.單卵雙胎間血紅蛋白檢查雙胎間血紅蛋白相差>50g/L,數值低者為失血兒。
3.母血片紅細胞酸洗脫試驗胎-母輸血診斷須在母血中,找到胎兒紅細胞或母血HbF>2%,為胎-母輸血。母血紅細胞塗片酸洗脫試驗是基於胎兒血紅蛋白在酸性緩衝液中有抗酸作用而保留在紅細胞內母血紅蛋白則被酸洗去成為空影細胞,此法不但可以發現胎兒紅細胞,還可大約估計新生兒失血量,是目前常用的檢查方法
(1)母血胎兒血紅蛋白定量檢查:正常成人血中胎兒血紅蛋白定量應<3%,在妊娠期,母血胎兒血紅蛋白有生理性增加,可高達5.7%,但其紅細胞酸洗脫後染呈淡紅色可與真正的胎兒紅細胞染呈鮮紅色相鑑別。
(2)甲胎蛋白(alphafetoprotein)定量檢查:胎-母輸血者,母血中甲胎蛋白值增加。
4.其他雙胎間輸血受血兒血液黏稠度增高和有高膽紅素血症。
其它輔助檢查:
B超檢查可發現肝、脾腫大,產前B超可見雙胎同性別、單個胎盤兩胎兒間有頭髮絲樣縱隔。失血胎兒生長遲緩可有羊水少;受血胎兒羊水多
治療
 醫療設施
醫療設施1.重度貧血治療
(1)輸血:嬰兒在生後24h內,靜脈血血紅蛋白<130g/L應輸血治療,速度應緩慢,每小時不超過2ml/kg。有充血性心力衰竭的病兒,為防止輸血引起血容量進一步增加,輸血前可靜脈注射呋塞米1mg/kg,對嚴重病例可用壓縮紅細胞進行部分交換輸血,所需壓縮紅細胞容量可按以下公式計算。
①NieburgandStockman公式(1977):
所需壓縮紅細胞(ml)=體重×75ml/kg×所需增加Hb/[22g/dl-Hbw]75ml/kg為平均血容量,22g/dl代表壓縮紅細胞的Hb濃度。
所需增加Hb=欲提高Hb到多少-目前患兒Hb濃度。
Hbwwww代表換血時所換出的Hb,由於每次抽血移出的Hb濃度不同,Hbwwww可按(換血前Hbg/dl+欲將Hb提高到的g/dl)/2計算。換血時每次抽血和注血量為血容量的5%是安全的。
舉例:患兒體重3kgHb3g/dl欲提高Hb至10g/dl。所需壓縮紅細胞(ml)=3kg×75ml/kg×(10-3)g/dl/[22-(3+10)/2]g/dl=101.6ml(約100ml)換血時每次抽血和注血各10ml。
②另一計算法:按每輸壓縮紅細胞2ml/kg可提高新生兒Hb0.5~1g/dl計算。
舉例:患兒體重3kg,Hb3g/dl欲提高:Hb至10g/dl尚差Hb7g/dl。
所需壓縮紅細胞=2ml/kg×3kg×(7g/dl/0.5~1g/dl)=42~84ml。
在實際換血時,每輸入一定容量壓縮紅細胞,尚需棄去等量的新生兒血液所丟失的Hb就需另用上述壓縮紅細胞量的一半補充,即再另加21~42ml,總共需壓縮紅細胞可按約60~120ml計算。
(2)其他急救措施:積極抗休克,抗心衰。分娩時急性胎-母大量失血所致的低血容量休克,需給氧吸入並緊急輸血擴充血容量,糾正休克,在血未準備好前,先立即從靜脈輸生理鹽水、血漿或5%人血白蛋白10~20ml/kg,繼之輸全血20ml/kg。在情況緊急時,可直接輸O型Rh陰性血,勿須交叉配血,以爭取搶救時間
2.中度貧血者治療給以鐵劑,元素鐵2~3mg/(kg·d),相當於2.5%硫酸亞鐵0.4~0.6ml/(kg·d),分3次口服,療程3個月,同時加服維生素C,應鶒在2次餵奶間服用。
3.其他治療治療併發症;有外科指征時外科止血。
預防
 保健食品
保健食品取決於失血的速度和程度,如急性重症失血,出現嚴重併發症者易造成死亡。雙胎輸血發生越早預後越差,如不治療圍產兒病死率可達100%;孕28周前診斷及處理者,圍產兒病死率在20%~45%,明顯高於雙羊膜囊、雙絨毛膜無胎兒間輸血的雙胎兒。
預防:
1.發生在產前的胎-母失血(是胎兒失血最常見類型)胎-胎輸血,病因和機制尚不明確發現羊膜穿刺,外倒轉,靜脈注射催產素和妊娠高血壓綜合徵時可發生,除積極防治妊娠高血壓綜合徵外,其他操作應慎重並注意鑑別本症的發生以及時採取有效診治措施。胎-胎輸血若能在產前確診,受血胎兒穿刺抽取過多的羊水,可緩解症狀,並為病因治療的方法。
2.發生在產時和產後的失血,應提高接生技術,加強圍生期保健防止難產和早產生後常規補充維生素K等均為有效措施。
兒科疾病
| 兒科病就是兒童易患疾病的統稱。比如腸胃疾病,營養不良,呼吸疾病等等。 |
